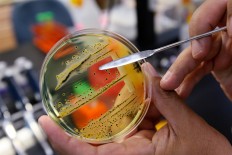
The dirty dozen: UN issues list of 12 most worrying bacteria

Popular Reads
No popular reads data found
Top Results
No results found. Please check your search term and try again
Can't find what you're looking for?
View all search resultsPopular Reads
No popular reads data found
Top Results
No results found. Please check your search term and try again
Can't find what you're looking for?
View all search resultsbacteria
Health 7 years ago
Scientists map genetic codes of 3,000 dangerous bacteria
Scientists seeking new ways to fight drug-resistant superbugs have mapped the genomes of more than 3,000 bacteria, including samples of a bug taken from Alexander Fleming's nose and a dysentery-causing strain from a World War One soldier.